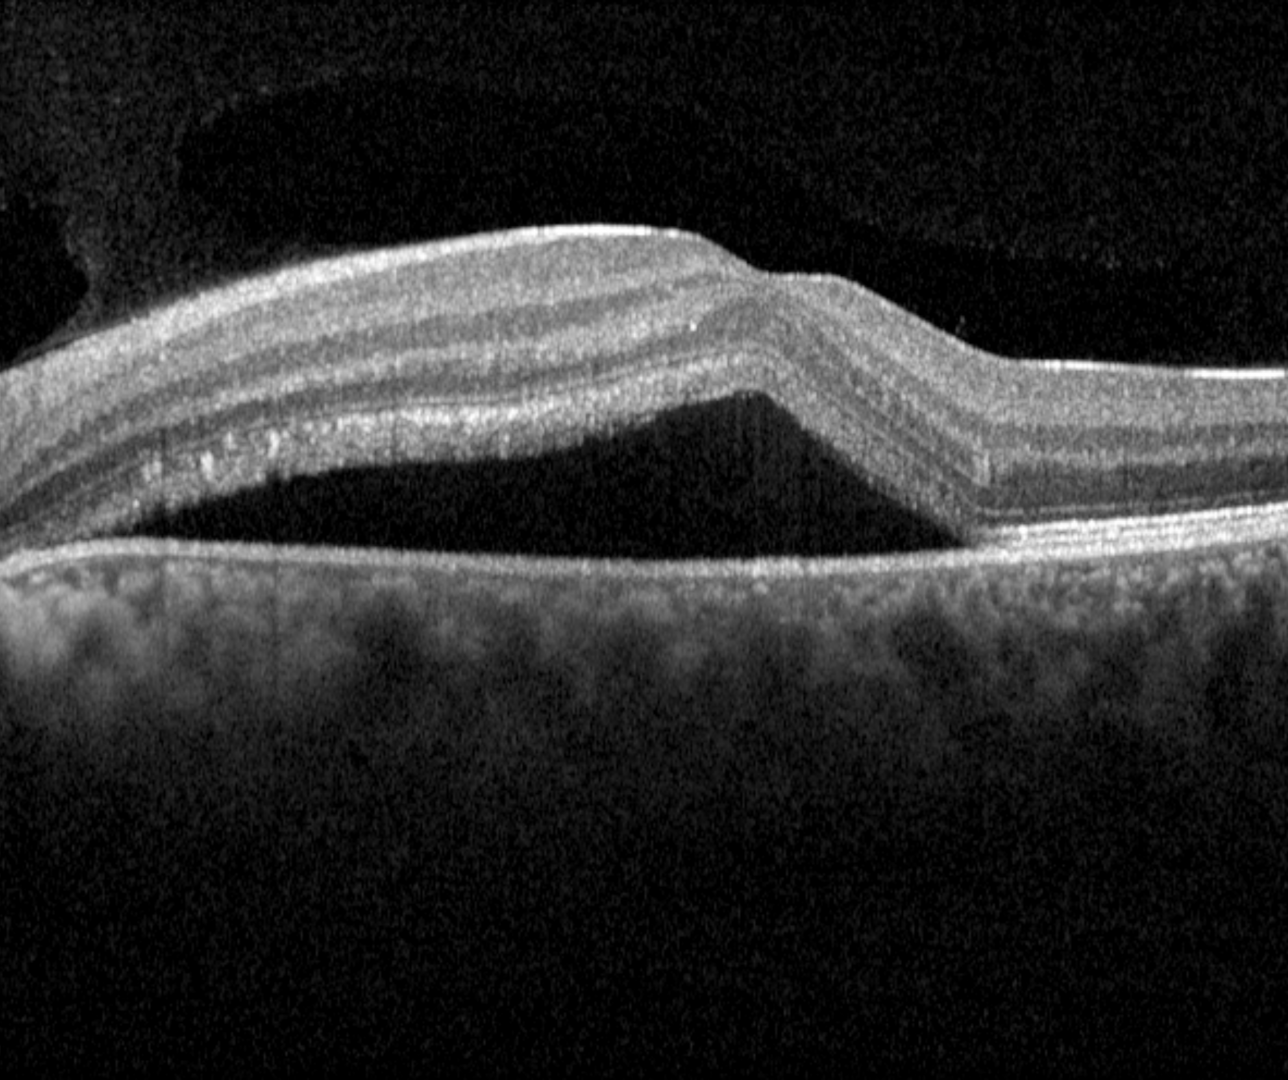

Overview
Acute central serous chorioretinopathy is characterised by the presence of a dome-shaped sub-retinal fluid (serous retinal detachment), typically associated with a serous pigment epithelial detachment. The sub-retinal fluid can cause symptoms of blur, metamorphopsia, and/or a mild hyperopic shift.
Acute CSCR has an acute onset and the sub-retinal fluid resolves over 3-6 months. CSCR lasting longer than 4 months is associated with elongated photoreceptor outer segments as seen on OCT. This is termed non-resolving CSCR. Subretinal fluid can return following complete resolution, and the new episode of acute CSCR is termed recurrent CSCR.
Long-standing CSCR can cause atrophic changes to the RPE. For more information about chronic CSCR, please click on the link at the bottom of this page.
There are several established risk factors for CSCR. Those with the strongest association include the following:
1. Gender - males have been found to be between 2.7 and 8 times more likely to develop CSCR than females (Haimovici et al 2004, Tittl et al 2003)
2. Stress (Bousquet et al 2016)
3. Maladaptive response to stress and anxiety (Bennett, 1955, Yannuzzi, 1987, Conrad et al. 2014)
4. Oral or intravenous corticosteroid use (Tittl et al. 1999, Haimovici et al. 2004)
Other risk factors may include systemic hypertension, hypercortisolism and pregnancy/pre-eclampsia.
Colour fundus photograph typically shows a raised macular appearance with pigmentary abnormalities.
OCT shows a well defined, dome-shaped, serous retinal detachment usually associated with a serous PED. The retinal layers are otherwise undisturbed in acute presentations, however, in cases of persistent subretinal fluid, elongation of the photoreceptor outer segments, subretinal fibrin, and subretinal yellowish dots can occur.
Fundus autofluorescence imaging can be normal or show diffuse or granular hyperautofluorescence depends on the duration of the serous detachment and the presence of subretinal materials.
Case Examples
-
Case 1
A 38-year-old Caucasian male complaining of blur and distortions in his central vision in the left eye as well as a central yellow circle. He is currently under a lot of stress at work. His best-corrected visual acuity in the left eye was 6/15-, not improving with a pinhole.
-
Case 2
A 29-year-old Middle Eastern male with best-corrected visual acuity in his left eye of 6/15-1. He reported elevated stress and anxiety recently.
Differential Diagnosis
References
Borooah, S, Sim, P.Y, Phatak, S, Moraes, G, Wu, C.Y, Cheung, CMG., Pal, B, Bujarborua, D. (2020), Pachychoroid spectrum disease. Acta Ophthalmol.
Cheung, CMG, Lee, WK, Koizumi, H. et al. Pachychoroid disease. Eye 33, 14–33 (2019).


